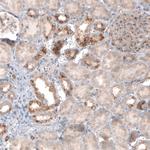
CLIP1 Antibody in Immunohistochemistry (Paraffin) (IHC (P))

Search
Invitrogen
CLIP1 Monoclonal Antibody (CL4844)
{{$productOrderCtrl.translations['antibody.pdp.commerceCard.promotion.promotions']}}
{{$productOrderCtrl.translations['antibody.pdp.commerceCard.promotion.viewpromo']}}
{{$productOrderCtrl.translations['antibody.pdp.commerceCard.promotion.promocode']}}: {{promo.promoCode}} {{promo.promoTitle}} {{promo.promoDescription}}. {{$productOrderCtrl.translations['antibody.pdp.commerceCard.promotion.learnmore']}}

Please note: We are reviewing Western blot images included in the antibody testing data in our catalog, including those provided by third parties. Unless expressly labeled or annotated as “raw-unedited”, Western blot images included in the antibody testing data in our catalog may have been edited, optimized or otherwise adjusted for presentation.
产品信息
MA5-31404
种属反应
宿主/亚型
分类
类型
克隆号
偶联物
形式
浓度
规格
纯化类型
保存液
内含物
保存条件
运输条件
RRID
产品详细信息
Immunogen sequence: KNLELQLKEN KRQLSSSSGN TDTQADEDER AQESQIDFLN SVIVDLQRKN QDLKMKVEMM SEAALNGNGD DLNNYDSDDQ EKQSKKKPRL FCDICDCFDL HDTEDCPTQA QMSEDPPHST HHGSRGEERP YCEICEMFGH WATNCNDDET
Highest antigen sequence indentity to the following orthologs: Rat - 95%, Mouse - 97%.
靶标信息
CLIP170 was initially identified as a new type of intermediate filament associated protein that is highly expressed in Reed-Sternberg cells, the tumoral cells diagnostic for Hodgkin's disease. Later experiments showed that it is located at microtubule plus ends and is required for the binding of endocytic carrier vesicles. CLIP170 has also been suggested to act with LIS1, a protein implicated in brain development, to regulate dynein/dynactin binding microtubules. Other studies suggest that CLIP170 can influence the formation of lamellipodia and cell invasion by invasive breast cancer cells by regulating the release of kinesin and IQGAP1 from a complex of those proteins, CLIP170 and Rac1. At least two isoforms of CLIP170 are known to exist.
仅用于科研。不用于诊断过程。未经明确授权不得转售。
篇参考文献 (0)
生物信息学
蛋白别名: CAP-Gly domain-containing linker protein 1; CLIP-170; Cytoplasmic linker protein 1; Cytoplasmic linker protein 170 alpha-2; MGC131604; Reed-Sternberg intermediate filament-associated protein; Restin
基因别名: CLIP1; CYLN1; RSN
Entrez Gene ID: (Human) 6249




